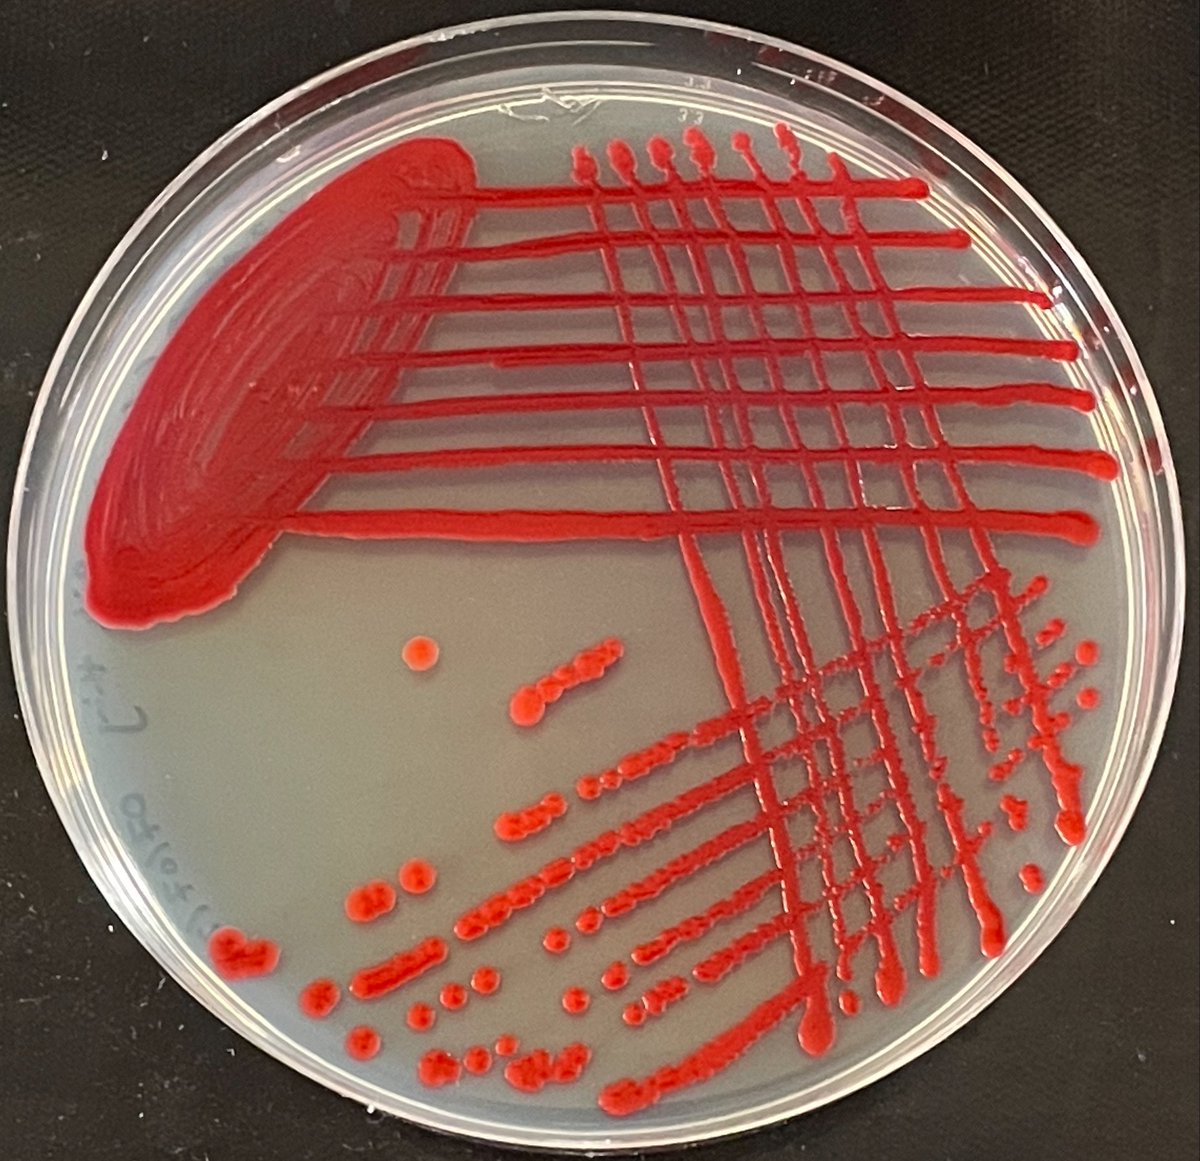
MicroMad tweet media

MicroMad retweetledi
MicroMad
62 posts

MicroMad
@Micro_Mad
Bringing microbiology to CoCoMad '23 | @imibirmingham | @unibirmingham 🧫
Birmingham Katılım Haziran 2023
46 Takip Edilen66 Takipçiler

@Micro_Mad Oh well 😀 something interesting pops up every time!
English

We saw a lot of diversity on these plates!
This photo is a great snapshot.
In just this small area, we can see at least 10 different colony types!
(Each structure is a colony)
It’s hard to identify microbes from their colonies alone, but here's a thread of our thoughts:

TheRealStu@TheRealStu1
@Micro_Mad @IMIBirmingham These are awesome! Whilst I'm not expecting one for every plate, could we have a description of some of the things we can see?
English

@DavidWiddick That'd be interesting! Sadly the plates have been disposed of now... next time we'll try this on any similar colonies we find
English

@Micro_Mad Also you could try coculturing it with some of the other organisms on the plate to see if it’s a response to those.
English

@Micro_Mad This is interesting. It you streak on from the centre of these colonies or one of the fingers?
English

@ClaireW36827493 That's what we like to hear!
We've posted a thread today with a bit more detail. Plate 140 has a couple of those hairy colonies that are probably Bacillus!
English

@Micro_Mad My 8yr old loved looking for hers (140) she now wants to know what all the different parts are! #superscience
English

@TheRealStu1 @IMIBirmingham We're glad to hear the boys enjoyed it!!
Check out today's thread, it covers the hairy stuff!
As for plates 59 and 60, it's interesting that they look more like one another than other plates in the collection! People who spend a lot of time together can share their microbes.
English

@Micro_Mad @IMIBirmingham 59 and 60. But not all plates are the same. I see red stuff, egg yolk/white like stuff on others. I bet there's a plethora of various cultures on them! The hairy stuff is intriguing too! Thanks for this. The boys really loved it.
English

We're about to start sharing photos of everyone's plates from #CoCoMAD ! 🧫🧫
Our plate photo studio is set up here at @IMIBirmingham , and we'll be posting throughout today - keep an eye out for your number!
English

@ElzeHesse @ContamClub We streaked a pink colony and left it at room temp over the weekend. Here's the result!
English

These colonies are amazing! The pink ones look like neurons 🧠😍
Has anyone ever seen anything growing like this? Any idea what they could be?
MicroMad@Micro_Mad
It was great to meet so many people at #CoCoMAD on Saturday! The plates have been growing in our lab @IMIBirmingham, and they're looking beautiful! Here are a couple that caught our eye - check back on Friday to find yours!
English

@TheRealStu1 @IMIBirmingham We can do that, which plate are you interested in? We will be posting some of our favourites next week!:)
English

@Micro_Mad @IMIBirmingham These are awesome! Whilst I'm not expecting one for every plate, could we have a description of some of the things we can see?
English

















